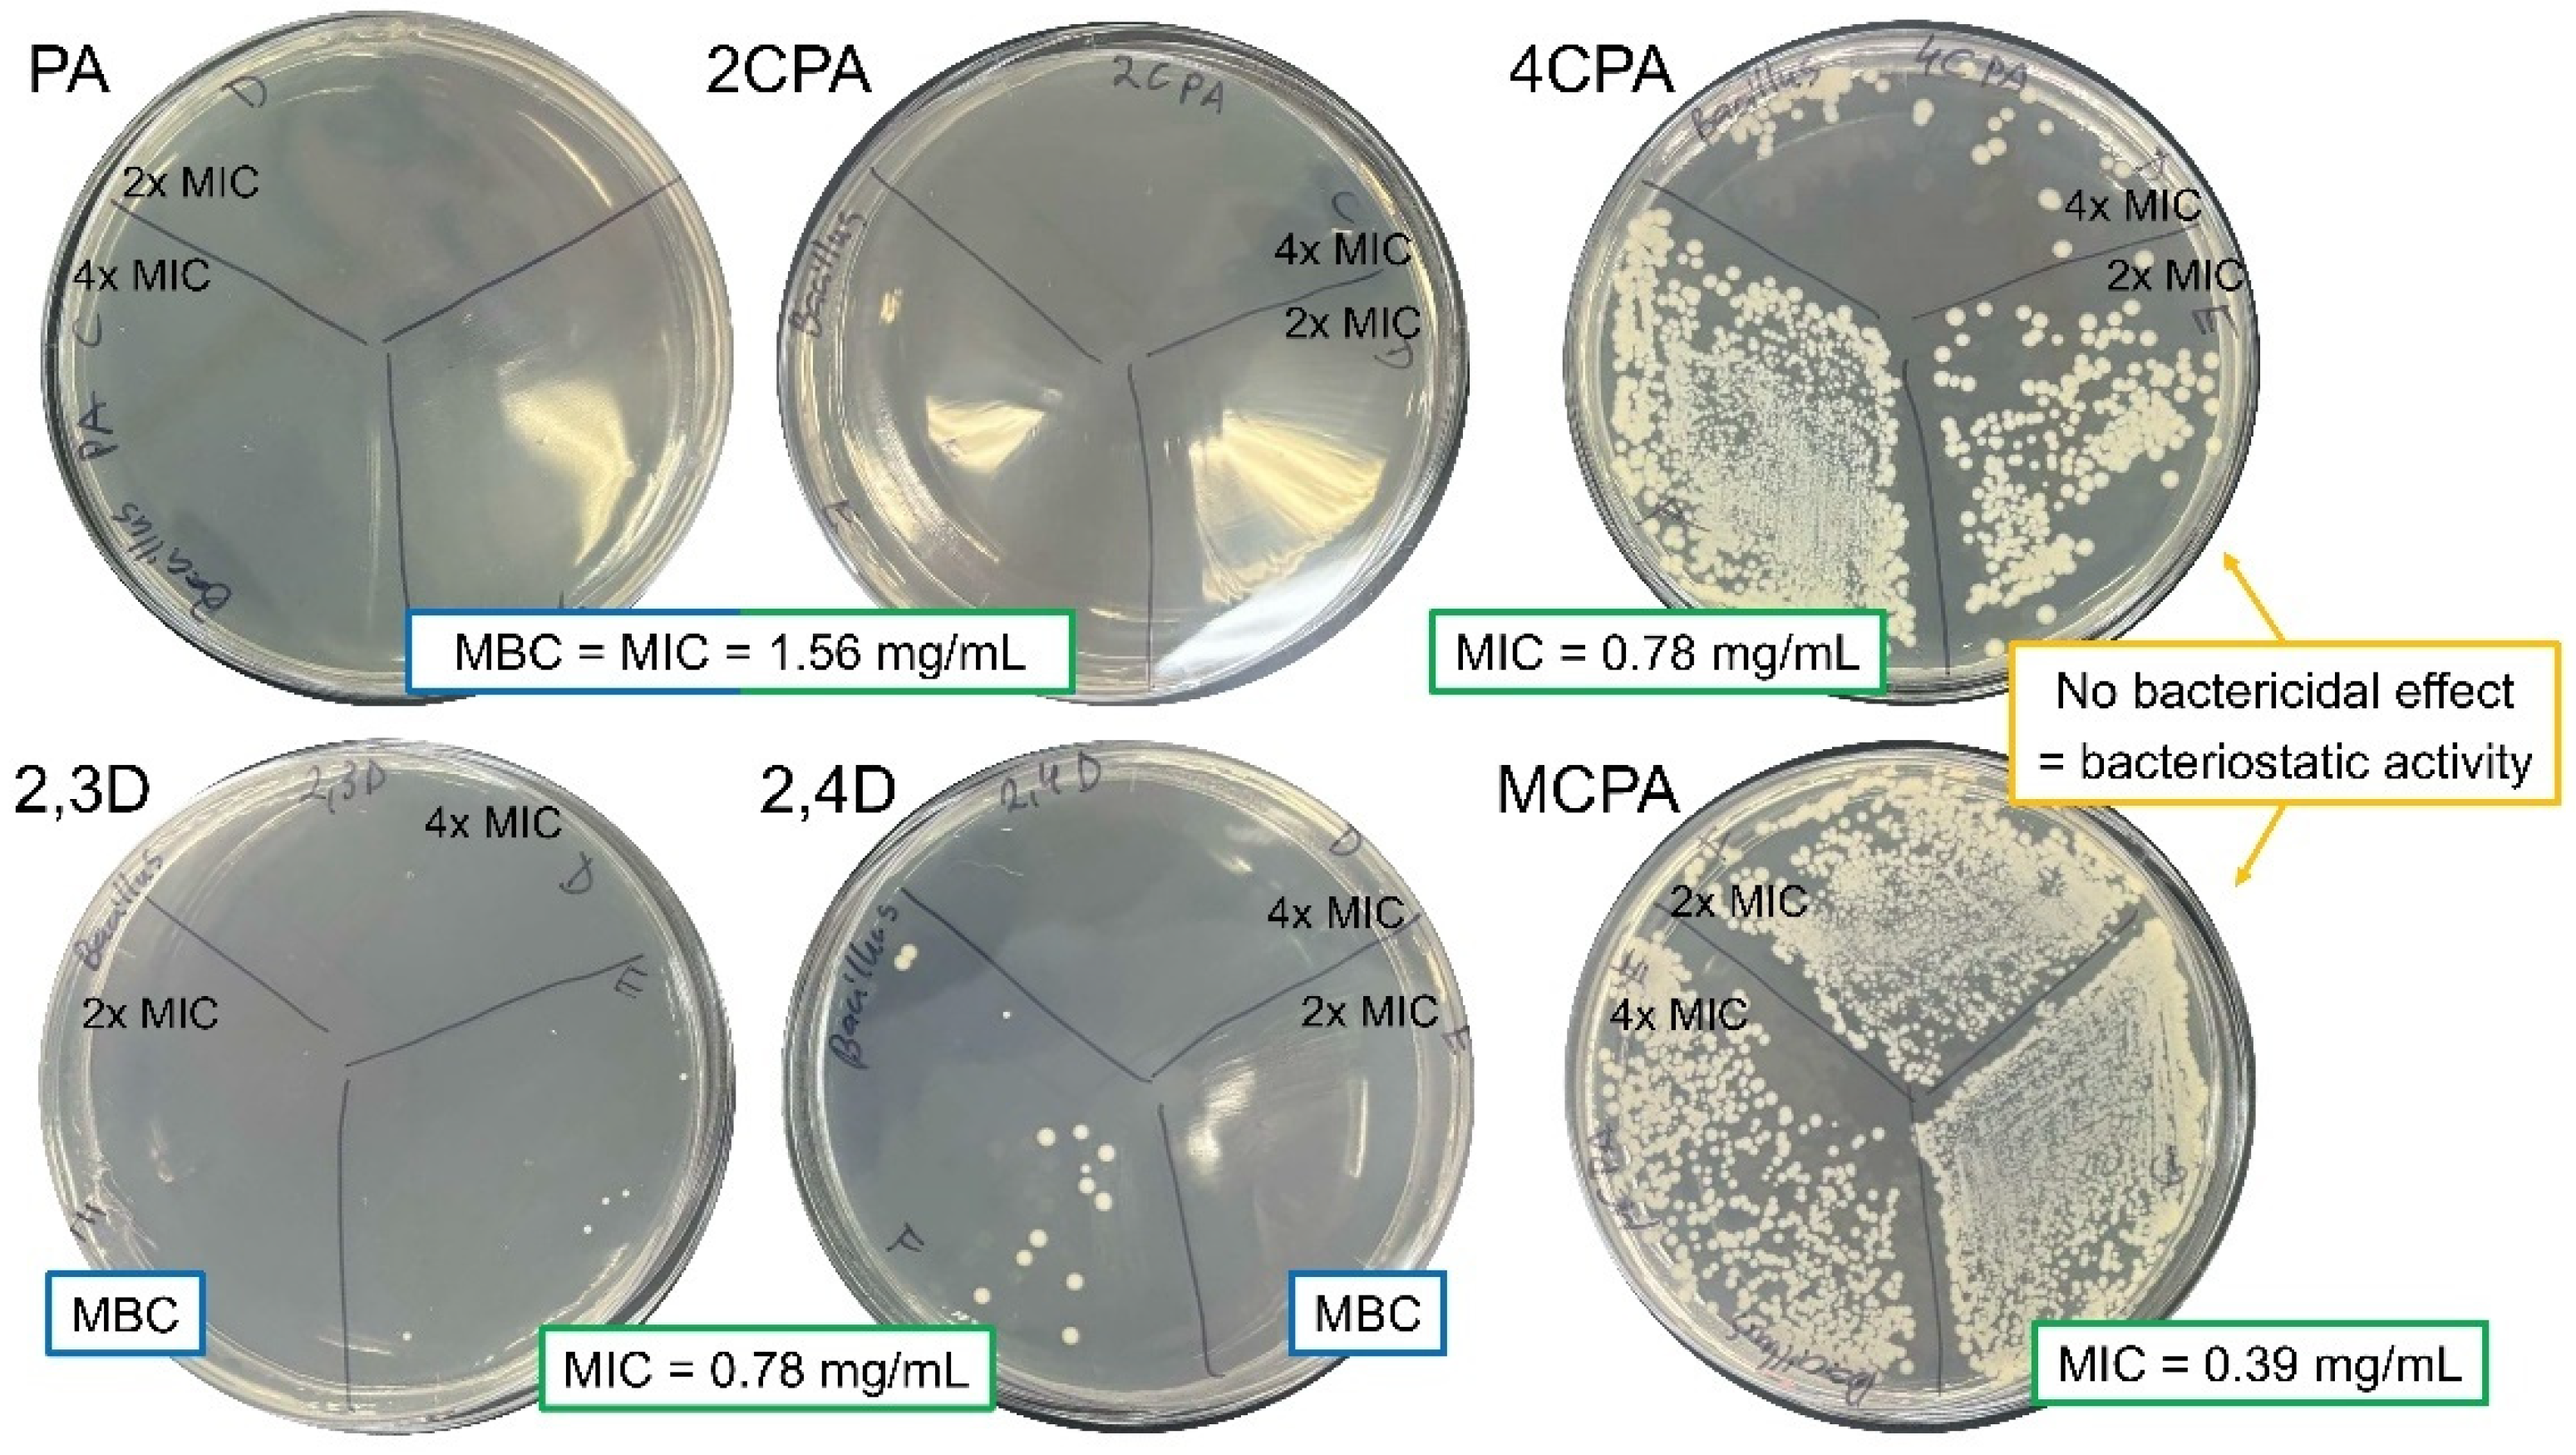
Materials 18 01680 g012

Study of the Relationship Between the Structures and Biological Activity of Herbicides Derived from Phenoxyacetic Acid
Abstract
1. Introduction
2. Materials and Methods
2.1. Theoretical Studies
2.1.1. Structures and Electronic Charge Distribution
2.1.2. Aromaticity
2.1.3. Reactivity
2.2. HO• Radical Inhibition Activity
2.3. Spectroscopic Studies
2.4. Antimicrobial Study
2.5. Cytotoxic Study
2.5.1. Cell Culture and Herbicides Treatment
2.5.2. Cell Viability Assay
2.5.3. Statistical Analysis
3. Results and Discussion
3.1. Theoretical Calculations
3.1.1. Structure and Aromaticity
3.1.2. HOMO-LUMO Orbitals
3.1.3. Electronic Charge Distribution
NBO and CHelpG
3.2. Results of Spectroscopic Studies
3.2.1. FTIR and FTRaman
3.2.2. UV-VIS Study
3.2.3. 13CNMR and 1HNMR
3.3. Results of Reactivity Studies
3.4. Antibacterial Activity
3.5. Cytotoxicity of Herbicides
4. Conclusions
Supplementary Materials
Author Contributions
Funding
Institutional Review Board Statement
Informed Consent Statement
Data Availability Statement
Conflicts of Interest
References
- Quareshy, M.; Prusinska, J.; Li, J.; Napier, R. A cheminformatics review of auxins as herbicides. J. Exp. Bot. 2018, 69, 265–275. [Google Scholar] [CrossRef] [PubMed]
- Bradberry, S.M.; Watt, B.E.; Proudfoot, A.T.; Vale, J.A. Mechanisms of toxicity, clinical features, and management of acute chlorophenoxy herbicide poisoning: A review. J. Toxicol.—Clin. Toxicol. 2000, 38, 111–122. [Google Scholar] [CrossRef]
- Bradberry, S.M.; Proudfoot, A.T.; Vale, J.A. Poisoning due to chlorophenoxy herbicides. Toxicol. Rev. 2004, 23, 65–73. [Google Scholar] [CrossRef] [PubMed]
- Paszko, T.; Muszyński, P.; Materska, M.; Bojanowska, M.; Kostecka, M.; Jackowska, I. Adsorption and degradation of phenoxyalkanoic acid herbicides in soils: A review. Environ. Toxicol. Chem. 2016, 35, 271–286. [Google Scholar] [CrossRef] [PubMed]
- Cheng, Z.; Zhang, C.; Jiang, W.; Zhai, W.; Gao, J.; Wang, P. Effects of the presence of triclocarban on the degradation and migration of co-occurring pesticides in soil. Environ. Pollut. 2022, 310, 119840. [Google Scholar] [CrossRef]
- Rose, M.T.; Cavagnaro, T.R.; Scanlan, C.A.; Rose, T.J.; Vancov, T.; Kimber, S.; Kennedy, I.R.; Kookana, R.S.; Van Zwieten, L. Impact of Herbicides on Soil Biology and Function. Adv. Agron. 2016, 136, 133–220. [Google Scholar] [CrossRef]
- Duchnowicz, P.; Koter, M.; Duda, W. Damage of erythrocyte by phenoxyacetic herbicides and their metabolites. Pestic. Biochem. Physiol. 2002, 74, 1–7. [Google Scholar] [CrossRef]
- Harishankar, M.K.; Sasikala, C.; Ramya, M. Efficiency of the intestinal bacteria in the degradation of the toxic pesticide, chlorpyrifos. 3 Biotech 2013, 3, 137–142. [Google Scholar] [CrossRef]
- Wołejko, E.; Łozowicka, B.; Kaczyński, P. Pesticide residues in berries fruits and juices and the potential risk for consumers. Desalination Water Treat. 2014, 52, 3804–3818. [Google Scholar] [CrossRef]
- Jabłońska-Trypuć, A.; Wołejko, E.; Wydro, U.; Butarewicz, A. The impact of pesticides on oxidative stress level in human organism and their activity as an endocrine disruptor. J. Environ. Sci. Health Part B 2017, 52, 483–494. [Google Scholar] [CrossRef]
- Alavanja, M.C.R.; Bonner, M.R. Pesticides and human cancers. Cancer Investig. 2005, 23, 700–711. [Google Scholar] [CrossRef] [PubMed]
- Sabarwal, A.; Kumar, K.; Singh, R.P. Hazardous effects of chemical pesticides on human health–Cancer and other associated disorders. Environ. Toxicol. Pharmacol. 2018, 63, 103–114. [Google Scholar] [CrossRef]
- Norouzi, F.; Alizadeh, I.; Faraji, M. Human exposure to pesticides and thyroid cancer: A worldwide systematic review of the literatures. Thyroid Res. 2023, 16, 13. [Google Scholar] [CrossRef]
- Mink, P.J.; Adami, H.O.; Trichopoulos, D.; Britton, N.L.; Mandel, J.S. Pesticides and prostate cancer: A review of epidemiologic studies with specific agricultural exposure information. Eur. J. Cancer Prev. 2008, 17, 97–110. [Google Scholar] [CrossRef] [PubMed]
- Ünal, F.; Yüzbaşíoǧlu, D.; Yílmaz, S.; Akíncí, N.; Aksoy, H. Genotoxic effects of chlorophenoxy herbicide diclofop-methyl in mice in vivo and in human lymphocytes in vitro. Drug Chem Toxicol. 2011, 34, 390–395. [Google Scholar] [CrossRef]
- Saracci, R.; Kogevinas, M.; Winkelmann, R.; Bertazzi, P.A.; Bueno de Mesquita, B.H.; Coggon, D.; Green, L.M.; Kauppinen, T.; L’Abbé, K.A.; Littorin, M.; et al. Cancer mortality in workers exposed to chlorophenoxy herbicides and chlorophenols. Lancet 1991, 338, 1027–1032. [Google Scholar] [CrossRef] [PubMed]
- Bellet, E.M.; Van Ravenzwaay, B.; Pigott, G.; Leeming, N. Chronic dietary toxicity and oncogenicity evaluation of MCPA (4-chloro-2-methylphenoxyacetic acid) in rodents. Regul. Toxicol. Pharmacol. 1999, 30, 223–232. [Google Scholar] [CrossRef]
- Von Stackelberg, K. A systematic review of carcinogenic outcomes and potential mechanisms from exposure to 2,4-D and MCPA in the environment. J. Toxicol. 2013, 2013, 371610. [Google Scholar] [CrossRef]
- Jote, C.A. A Review of 2,4-D Environmental Fate, Persistence and Toxicity Effects on Living Organisms. Org. Med. Chem. Int. J. 2019, 9, 555755. [Google Scholar] [CrossRef]
- Goodman, J.E.; Loftus, C.T.; Zu, K. 2,4-Dichlorophenoxyacetic acid and non-Hodgkin’s lymphoma, gastric cancer, and prostate cancer: Meta-analyses of the published literature. Ann. Epidemiol. 2015, 25, 626–636.e4. [Google Scholar] [CrossRef]
- Kogevinas, M.; Becher, H.; Benn, T.; Bertazzi, P.A.; Boffetta, P.; Bueno-de-Mesqurta, H.B.; Coggon, D.; Colin, D.; Flesch-Janys, D.; Fingerhut, M.; et al. Cancer mortality in workers exposed to phenoxy herbicides, chlorophenols, and dioxins: An expanded and updated International Cohort Study. Am. J. Epidemiol. 1997, 145, 1061–1075. [Google Scholar] [CrossRef] [PubMed]
- Elliott, B. Review of the genotoxicity of 4-chloro-2-methylphenoxyacetic acid. Mutagenesis 2005, 20, 3–13. [Google Scholar] [CrossRef] [PubMed]
- Garabrant, D.H.; Philbert, M.A. Review of 2,4-dichlorophenoxyacetic acid (2,4-D) epidemiology and toxicology. Crit. Rev. Toxicol. 2002, 32, 233–257. [Google Scholar] [CrossRef]
- Mena, S.; Ortega, A.; Estrela, J.M. Oxidative stress in environmental-induced carcinogenesis. Genet. Toxicol. Environ. Mutagen. 2009, 674, 36–44. [Google Scholar] [CrossRef]
- Sule, R.O.; Condon, L.; Gomes, A.V. A Common Feature of Pesticides: Oxidative Stress—The Role of Oxidative Stress in Pesticide-Induced Toxicity. Oxidative Med. Cell. Longev. 2022, 2022, 5563759. [Google Scholar] [CrossRef] [PubMed]
- Bukowska, B. Toxicity of 2,4-dichlorophenoxyacetic acid—Molecular mechanisms. Pol. J. Environ. Stud. 2006, 1, 365–374. [Google Scholar]
- Grossmann, K.; Scheltrup, F.; Kwiatkowski, J.; Caspar, G. Induction of abscisic acid is a common effect of auxin herbicides in susceptible plants. J. Plant Physiol. 1996, 149, 475–478. [Google Scholar] [CrossRef]
- Cabral, M.G.; Viegas, C.A.; Teixeira, M.C.; Sá-Correia, I. Toxicity of chlorinated phenoxyacetic acid herbicides in the experimental eukaryotic model Saccharomyces cerevisiae: Role of pH and of growth phase and size of the yeast cell population. Chemosphere 2003, 51, 47–54. [Google Scholar] [CrossRef]
- Zafeiridou, G.; Geronikaki, A.; Papaefthimiou, C.; Tryfonos, M.; Kosmidis, E.K.; Theophilidis, G. Assessing the effects of the three herbicides acetochlor, 2,4,5-trichlorophenoxyacetic acid (2,4,5-T) and 2,4-dichlorophenoxyacetic acid on the compound action potential of the sciatic nerve of the frog (Rana ridibunda). Chemosphere 2006, 65, 1040–1048. [Google Scholar] [CrossRef]
- Sixt, S.; Altschuh, J.; Brüggemann, R. Quantitative structure-toxicity relationships for 80 chlorinated compounds using quantum chemical descriptors. Chemosphere 1995, 30, 2397–2414. [Google Scholar] [CrossRef]
- Fei, J.; Mao, Q.; Peng, L.; Ye, T.; Yang, Y.; Luo, S. The internal relation between quantum chemical descriptors and empirical constants of polychlorinated compounds. Molecules 2018, 23, 2935. [Google Scholar] [CrossRef] [PubMed]
- Putz, M.V.; Putz, A.M. DFT chemical reactivity driven by biological activity: Applications for the toxicological fate of chlorinated PAHs. In Applications of Density Functional Theory to Biological and Bioinorganic Chemistry; Springer: Berlin/Heidelberg, Germany, 2013; Volume 150. [Google Scholar] [CrossRef]
- Nevalainen, T.; Kolehmainen, E. New qsar models for polyhalogenated aromatics. Environ. Toxicol. Chem. 1994, 13, 1699–1706. [Google Scholar] [CrossRef]
- Padmanabhan, J.; Parthasarathi, R.; Subramanian, V.; Chattaraj, P.K. Molecular structure, reactivity, and toxicity of the complete series of chlorinated benzenes. J. Phys. Chem. A 2005, 109, 11043–11049. [Google Scholar] [CrossRef] [PubMed]
- Geerlings, P.; De Proft, F.; Langenaeker, W. Conceptual density functional theory. Chem. Rev. 2003, 103, 1793–1874. [Google Scholar] [CrossRef]
- Wolinski, K.; Hinton, J.F.; Pulay, P. Efficient Implementation of the Gauge-Independent Atomic Orbital Method for NMR Chemical Shift Calculations. J. Am. Chem. Soc. 1990, 112, 8251–8260. [Google Scholar] [CrossRef]
- Weinhold, F.; Landis, C.R. Natural Bond Orbitals And Extensions Of Localized Bonding Concepts. Chem. Educ. Res. Pract. 2001, 2, 91–104. [Google Scholar] [CrossRef]
- Breneman, C.M.; Wiberg, K.B. Determining atom-centered monopoles from molecular electrostatic potentials. The need for high sampling density in formamide conformational analysis. J. Comput. Chem. 1990, 11, 361–373. [Google Scholar] [CrossRef]
- Julg, A.; François, P. Recherches sur la géométrie de quelques hydrocarbures non-alternants: Son influence sur les énergies de transition, une nouvelle définition de l’aromaticité. Theor. Chim. Acta 1967, 8, 249–259. [Google Scholar] [CrossRef]
- Krygowski, T.M.; Ciesielski, A.; Bird, C.W.; Kotschy, A. Aromatic Character of the Benzene Ring Present in Various Topological Environments in Benzenoid Hydrocarbons. Nonequivalence of Indices of Aromaticity. J. Chem. Inf. Comput. Sci. 1995, 35, 203–210. [Google Scholar] [CrossRef]
- Krygowski, T.M.; Cyrański, M. Separation of the energetic and geometric contributions to the aromaticity of π-electron carbocyclics. Tetrahedron 1996, 52, 1713–1722. [Google Scholar] [CrossRef]
- Bird, C.W. A new aromaticity index and its application to five-membered ring heterocycles. Tetrahedron 1985, 41, 1409–1414. [Google Scholar] [CrossRef]
- Liu, Y.; Sun, B. Unusual Catalytic Effect of Fe3+ on 2,4-dichlorophenoxyacetic Acid Degradation by Radio Frequency Discharge in Aqueous Solution. Water 2022, 14, 1719. [Google Scholar] [CrossRef]
- Frisch, M.J.; Trucks, G.W.; Schlegel, H.B.; Scuseria, G.E.; Robb, M.A.; Cheeseman, J.R.; Scalmani, G.; Barone, V.; Mennucci, B.; Petersson, G.A.; et al. Gaussian 09, Revision A.02; Gaussian, Inc.: Wallingford, CT, USA, 2009. [Google Scholar]
- SXiong, L.; Li, A.; Huang, N.; Lu, F.; Hou, D. Antioxidant and immunoregulatory activity of different polysaccharide fractions from tuber of Ophiopogon japonicus. Carbohydr. Polym. 2011, 86, 1273–1280. [Google Scholar] [CrossRef]
- Karcz, D.; Starzak, K.; Ciszkowicz, E.; Lecka-Szlachta, K.; Kamiński, D.; Creaven, B.; Miłoś, A.; Jenkins, H.; Ślusarczyk, L.; Matwijczuk, A. Design, Spectroscopy, and Assessment of Cholinesterase Inhibition and Antimicrobial Activities of Novel Coumarin–Thiadiazole Hybrids. Int. J. Mol. Sci. 2022, 23, 6314. [Google Scholar] [CrossRef] [PubMed]
- Dżugan, M.; Ciszkowicz, E.; Tomczyk, M.; Miłek, M.; Lecka-Szlachta, K. Coniferous Honeydew Honey: Antibacterial Activity and Anti-Migration Properties Against Breast Cancer Cell Line (MCF-7). Appl. Sci. 2024, 14, 710. [Google Scholar] [CrossRef]
- Miłek, M.; Ciszkowicz, E.; Tomczyk, M.; Sidor, E.; Zaguła, G.; Lecka-Szlachta, K.; Pasternakiewicz, A.; Dżugan, M. The Study of Chemical Profile and Antioxidant Properties of Poplar-Type Polish Propolis Considering Local Flora Diversity in Relation to Antibacterial and Anticancer Activities in Human Breast Cancer Cells. Molecules 2022, 27, 725. [Google Scholar] [CrossRef]
- El-Nahass, M.M.; Kamel, M.A.; El-Deeb, A.F.; Atta, A.A.; Huthaily, S.Y. Ab initio HF, DFT and experimental (FT-IR) investigation of vibrational spectroscopy of P-N,N-dimethylaminobenzylidenemalononitrile (DBM). Spectrochim. Acta A Mol. Biomol. Spectrosc. 2011, 79, 443–450. [Google Scholar] [CrossRef]
- Frontier Orbitals and Organic Chemical Reactions. J. Mol. Struct. 1979, 56, 306. [CrossRef]
- Fleming, I. Molecular Orbitals and Organic Chemical Reactions, Reference Edition; Wiley: Hoboken, NJ, USA, 2010. [Google Scholar] [CrossRef]
- El-Gammal, O.A.; Rakha, T.H.; Metwally, H.M.; El-Reash, G.M.A. Synthesis, characterization, DFT and biological studies of isatinpicolinohydrazone and its Zn(II), Cd(II) and Hg(II) complexes. Spectrochim. Acta A Mol. Biomol. Spectrosc. 2014, 127, 144–156. [Google Scholar] [CrossRef]
- Arjunan, V.; Devi, L.; Subbalakshmi, R.; Rani, T.; Mohan, S. Synthesis, vibrational, NMR, quantum chemical and structure-activity relation studies of 2-hydroxy-4-methoxyacetophenone. Spectrochim. Acta A Mol. Biomol. Spectrosc. 2014, 130, 164–177. [Google Scholar] [CrossRef]
- Choudhary, V.K.; Bhatt, A.K.; Dash, D.; Sharma, N. DFT calculations on molecular structures, HOMO–LUMO study, reactivity descriptors and spectral analyses of newly synthesized diorganotin(IV) 2-chloridophenylacetohydroxamate complexes. J. Comput. Chem. 2019, 40, 2354–2363. [Google Scholar] [CrossRef]
- Pearson, R.G. Chemical hardness and density functional theory. J. Chem. Sci. 2005, 117, 369–377. [Google Scholar] [CrossRef]
- Luque, F.J.; López, J.M.; Orozco, M. Perspective on Electrostatic interactions of a solute with a continuum. A direct utilization of ab initio molecular potentials for the prevision of solvent effects. Theor. Chem. Acc. 2000, 103, 343–345. [Google Scholar] [CrossRef]
- Parthasarathi, R.; Sarkar, U.; Subramanian, V.; Chattaraj, P.K.; Maiti, B. Toxicity Analysis of Benzidine Through Chemical Reactivity and Selectivity Profiles: A DFT Approach. Internet Electron. J. Mol. Des. 2003, 2, 798–813. [Google Scholar]
- Zarjani, J.K.; Aliasgharzad, N.; Oustan, S.; Emadi, M.; Ahmadi, A. Isolation and characterization of potassium solubilizing bacteria in some Iranian soils. Arch. Agron. Soil Sci. 2013, 59, 1713–1723. [Google Scholar] [CrossRef]
- Chandra, H.; Kumari, P.; Bisht, R.; Prasad, R.; Yadav, S. Plant growth promoting Pseudomonas aeruginosa from Valeriana wallichii displays antagonistic potential against three phytopathogenic fungi. Mol. Biol. Rep. 2020, 47, 6015–6026. [Google Scholar] [CrossRef] [PubMed]
- Zhao, Y.; Mao, X.; Zhang, M.; Yang, W.; Di, H.J.; Ma, L.; Liu, W.; Li, B. The application of Bacillus megaterium alters soil microbial community composition, bioavailability of soil phosphorus and potassium, and cucumber growth in the plastic shed system of North China. Agric. Ecosyst. Environ. 2021, 307, 107236. [Google Scholar] [CrossRef]
- Pardo, L.A.; Beane Freeman, L.E.; Lerro, C.C.; Andreotti, G.; Hofmann, J.N.; Parks, C.G.; Koutros, S. Pesticide exposure and risk of aggressive prostate cancer among private pesticide applicators. Environ. Health 2020, 19, 30. [Google Scholar] [CrossRef]
- Jayakody, N.; Harris, E.C.; Coggon, D. Phenoxy herbicides, soft-tissue sarcoma and non-Hodgkin lymphoma: A systematic review of evidence from cohort and case-control studies. Br. Med. Bull. 2015, 114, 75–94. [Google Scholar] [CrossRef]
- Bond, G.G.; Bodner, K.M.; Cook, R.R. Phenoxy herbicides and cancer: Insufficient epidemiologic evidence for a causal relationship. Fundam. Appl. Toxicol. 1989, 12, 172–188. [Google Scholar] [CrossRef]
- Feodorova, Y.; Tomova, T.; Minchev, D.; Turiyski, V.; Draganov, M.; Argirova, M. Cytotoxic effect of Ginkgo biloba kernel extract on HCT116 and A2058 cancer cell lines. Heliyon 2020, 6, e04941. [Google Scholar] [CrossRef]

| PA | 2CPA | 4CPA | 2,3D | 2,4D | MCPA | |
|---|---|---|---|---|---|---|
| Energy [eV] | −14,571.57 | −27,078.42 | −27,078.52 | −39,585.24 | −39,585.33 | −28,148.71 |
| −14,571.91 | −27,078.81 | −27,078.87 | −39,585.64 | −39,585.72 | −28,149.05 | |
| Dipole moment [D] | 2.48 | 3.97 | 3.04 | 4.97 | 4.01 | 2.99 |
| 3.69 | 5.83 | 4.33 | 7.21 | 5.78 | 4.16 | |
| EHOMO [eV] | −9.2668 | −8.2034 | −8.0899 | −7.9120 | −7.9340 | −8.0755 |
| −9.2603 | −8.2034 | −8.0897 | −7.9226 | −7.9346 | −8.0744 | |
| ELUMO [eV] | −5.1859 | −4.8077 | −5.1767 | −4.5391 | −4.7868 | −5.0700 |
| −5.1870 | −4.8134 | −5.1789 | −4.5438 | −4.7922 | −5.0725 | |
| Δ = ELUMO − EHOMO [eV] | 4.0809 | 3.3957 | 2.9133 | 3.3729 | 3.1473 | 3.0055 |
| 4.0733 | 3.3900 | 2.9108 | 3.3788 | 3.1424 | 3.0020 | |
| Ionisation potential I = −EHOMO | 9.2668 | 8.2034 | 8.0899 | 7.9120 | 7.9340 | 8.0755 |
| 9.2603 | 8.2034 | 8.0897 | 7.9226 | 7.9346 | 8.0744 | |
| Electron affinity A = −ELUMO | 5.1859 | 4.8077 | 5.1767 | 4.5391 | 4.7868 | 5.0700 |
| 5.1870 | 4.8134 | 5.1789 | 4.5438 | 4.7922 | 5.0725 | |
| Electroegativity Χ = (I + A)/2 | 7.2264 | 6.5056 | 6.6333 | 6.2256 | 6.3604 | 6.5728 |
| 7.2237 | 6.5084 | 6.6343 | 6.2332 | 6.3634 | 6.5735 | |
| Chemical potential μ = −(I + A)/2 | −7.2264 | −6.5056 | −6.6333 | −6.2256 | −6.3604 | −6.5728 |
| −7.2237 | −6.5084 | −6.6343 | −6.2332 | −6.3634 | −6.5735 | |
| Chemical hardness η = (I − A)/2 | 2.0404 | 1.6979 | 1.4566 | 1.6864 | 1.5736 | 1.5027 |
| 2.0366 | 1.6950 | 1.4554 | 1.6894 | 1.5712 | 1.5010 | |
| Chemical softness S = 1/(2η) | 0.2450 | 0.2945 | 0.3433 | 0.2965 | 0.3177 | 0.3327 |
| 0.2455 | 0.2950 | 0.3435 | 0.2960 | 0.3182 | 0.3331 | |
| Electrophilicity index ω = μ2/2η | 12.7964 | 12.4635 | 15.1037 | 11.4910 | 12.8539 | 14.3741 |
| 12.8107 | 12.4955 | 15.1208 | 11.4988 | 12.8860 | 14.3940 | |
| Aromaticity indices | ||||||
| HOMA | 0.983 | 0.978 | 0.986 | 0.969 | 0.979 | 0.974 |
| 0.980 | 0.979 | 0.986 | 0.973 | 0.981 | 0.971 | |
| 0.987 | 0.711 | 0.972 | 0.990 | 0.981 | 0.912 | |
| GEO | 0.005 | 0.009 | 0.007 | 0.013 | 0.012 | 0.014 |
| 0.004 | 0.008 | 0.006 | 0.011 | 0.010 | 0.014 | |
| 0.009 | 0.986 | 0.014 | 0.009 | 0.016 | 0.071 | |
| EN | 0.012 | 0.013 | 0.008 | 0.017 | 0.009 | 0.012 |
| 0.016 | 0.014 | 0.009 | 0.016 | 0.009 | 0.014 | |
| 0.004 | 0.001 | 0.014 | 0.001 | 0.003 | 0.016 | |
| I6 | 96.16 | 95.01 | 95.73 | 93.97 | 94.49 | 93.95 |
| 96.69 | 95.48 | 95.98 | 94.56 | 94.78 | 93.77 | |
| 94.91 | 71.66 | 93.84 | 95.02 | 93.45 | 85.75 | |
| Aj | 0.998 | 0.996 | 0.997 | 0.994 | 0.995 | 0.994 |
| 0.998 | 0.997 | 0.997 | 0.995 | 0.995 | 0.993 | |
| 0.996 | 0.870 | 0.993 | 0.996 | 0.993 | 0.968 | |
| BAC | 0.930 | 0.920 | 0.928 | 0.913 | 0.917 | 0.903 |
| 0.939 | 0.927 | 0.935 | 0.924 | 0.923 | 0.905 | |
| 0.900 | 0.525 | 0.907 | 0.906 | 0.885 | 0.749 | |
| Phenoxyacetic Acid | 2-Chlorophenoxyacetic Acid | 4-Chlorophenoxyacetic Acid | Assignments | |||||||||||||
|---|---|---|---|---|---|---|---|---|---|---|---|---|---|---|---|---|
| Experimental | Calculated | Experimental | Calculated | Experimental | Calculated | |||||||||||
| FTIRKBR | FTIRATR | Raman | IR | Inten. | FTIRKBR | FTIRATR | Raman | IR | Inten. | FTIRKBR | FTIRATR | Raman | IR | Inten. | ||
| 3443 m | 3690 | 91.51 | 3431 m | 3690 | 95.09 | 3425 m | 3690 | 96.81 | ν(OH) | |||||||
| 3060 m | 3064 vw | 3060 s | 3136 | 1.17 | 3063 m | 3060 s | 3144 | 4.28 | 3054 m | 3066 vs | 3145 | 4.12 | 2 | ν(CH) | ||
| 3036 m | 3038 w | 3133 | 8.95 | 3039 m | 3137 | 7.71 | 3131 | 2.95 | 20a | ν(CH) | ||||||
| 3012 m | 3010 vw | 3013 vw | 3125 | 22.10 | 3003 m | 2999 w | 3125 | 10.63 | 3128 | 3.55 | 20b | ν(CH) | ||||
| 2921 m | 2920 w | 2923 w | 2973 | 13.31 | 2920 m | 2918 vw | 2920 m | 2983 | 11.19 | 2925 m | 2916 m | 2976 | 12.43 | νasCH2 | ||
| 2799 m | 2804 vw | 2940 | 33.02 | 2792 m | 2795 xw | 2947 | 31.92 | 2781 w | 2788 w | 2942 | 33.57 | νsCH2 | ||||
| 1736 s | 1732 m | 1742 s | 1742 m | 1743 s | 1743 s | νC=O | ||||||||||
| 1703 s | 1702 s | 1814 | 310.86 | 1712 s | 1711 m | 1819 | 295.01 | 1708 m | 1706 m | 1815 | 312.41 | νC=O | ||||
| 1599 m | 1597 w | 1598 m | 1609 | 70.23 | 1597 | 45.82 | 1647 w | 1604 | 27.11 | 9a | β(CH), ν(CC) | |||||
| 1585 m | 1585 w | 1585 m | 1592 | 30.04 | 1589 m | 1587 w | 1589 m | 1582 | 6.23 | 1599 w | 1598 m | 1584 | 13.86 | 9b | β(CH), ν(CC), | |
| 1498 s | 1498 m | 1487 vw | 1495 | 95.42 | 1485 vs | 1485 s | 1487 | 111.86 | 1494 s | 1494 s | 1491 w | 1491 | 189.33 | 18a | β(CH), ν(CC) | |
| 1470 w | 1470 w | 1459 w | 1458 | 17.31 | 1444 | 2.37 | 18b | β(CH), ν(CC)+ β CH2 | ||||||||
| 1437 s | 1437 m | 1439 m | 1452 | 39.72 | 1447 m | 1446 w | 1445 | 67.46 | 1427 s | 1427 m | 1431 m | 1454 | 73.85 | βCH2 | ||
| 1402 | 11.07 | 1400 m | 1400 m | 1409 w | 1398 | 12.42 | γCH2 | |||||||||
| 1374 w | 1374 m | 1381 w | 1399 | 11.26 | 1383 m | 1374 w | 1383 m | 1378 m | 1389 w | γCH2, νCCal, | ||||||
| 1338 w | 1341 w | 1339 w | 1330 | 17.21 | 1365 w | 1364 w | 1296 | 5.03 | 3 | β(CH), ν(CC) | ||||||
| 1310 m | 1310 w | 1310 vw | 1305 | 33.09 | 1313 m | 1303 | 49.38 | 1297 m | 1297 m | 1285 vw | 1300 | 73.60 | 8b | β(CH), ν(CC) | ||
| 1300 m | 1307 w | 1306 vw | 1282 | 4.97 | 1288 | 11.89 | 1283 | 0.74 | β(OH), γCH2 | |||||||
| 1289 m | 1289 w | 1289 w | 1248 | 275.65 | 1290 s | 1290 m | 1273 | 98.39 | 1249 | 289.97 | β(CH), RC-O, γCH2 | |||||
| 1266 m | 1267 w | 1233 | 1.93 | 1253 | 2.07 | 1234 | 2.15 | τCH2 | ||||||||
| 1245 vs | 1245 s | 1255 w | 1246 vs | 1246 vs | 1253 w | α(CCC), νC-O | ||||||||||
| 1235 vs | 1229 vs | 1239 vs | 1238 vs | 1231 vw | 1125 | 260.30 | α(CCC), νC-O | |||||||||
| 1184 m | 1185 w | 1185 vw | 1173 | 10.40 | 1163 | 14.50 | 1194 vs | 1194 s | 1171 | 12.15 | 8a | β(CH) | ||||
| 1172 m | 1172 w | 1174 w | 1156 | 1.77 | 1167 m | 1167 w | 1168 m | 1119 | 26.35 | 1107 | 36.83 | 14 | β(CH) | |||
| 1158 m | 1160 m | 1160 w | 1124 | 238.79 | 1137 m | 1137 w | 1142 w | 1082 | 305.35 | 1137 s | 1137 s | νC-OH, βCH2, βOH, | ||||
| 1093 s | 1093 m | 1085 | 178.43 | 1090 s | 1089 s | 1091 w | 1099 m | 1100 m | 1098 m | β(CH), βOH, | ||||||
| 1073 m | 1073 m | 1075 w | 1076 | 106.13 | 1051 m | 1052 m | 1078 m | 1079 m | 1078 w | 1072 | 233.93 | β(CH), νO-CH2 | ||||
| 1037 m | 1038 m | 1039 s | β(CH) | |||||||||||||
| 1022 w | 1022 w | 1028 w | 1023 | 2.08 | 1015 w | 1048 | 7.54 | 1018 w | 1018 w | 1002 | 15.64 | 19a | β(CH), ν(CC) | |||
| 997 w | 995 w | 996 s | 991 | 0.94 | 1040 | 43.02 | 996 w | 995 w | 1004 vw | 12 | α(CCC) | |||||
| 961 w | 961 w | 963 w | 967 | 0.14 | 956 m | 950 m | 949 | 0.11 | 5 | γ(CH) | ||||||
| 930 w | 931 w | 934 vw | 949 | 0.14 | 937 m | 940 m | 932 w | 958 | 0.19 | 927 m | 920 vw | 916 | 0.18 | 10b | γ(CH) | |
| 913 w | 915 w | 914 w | 885 | 2.47 | 913 m | 913 m | 918 m | 913 m | 885 | 4.56 | βO-CH2 | |||||
| 885 w | 888 w | 884 vw | 875 | 6.97 | 919 | 2.42 | 878 m | 878 m | 821 | 57.00 | 17b | γ(CH) | ||||
| 834 m | 835 w | 829 w | 820 | 22.91 | 840 m | 840 m | 841 w | 827 | 13.21 | 825 | 3.77 | 6a | α(CCC) | |||
| 821 m | 823 w | 823 w | 809 | 0.36 | 821 w | 823 w | 834 | 0.35 | 801 s | 803 vs | 791 | 12.02 | 10a | γ(CH) | ||
| 755 s | 755 s | 758 vw | 749 | 68.56 | 756 vs | 755 vs | 756 vw | 745 | 66.78 | 755 vw | 755 w | 11 | γ(CH) | |||
| 715 m | 716 s | 706 w | 721 vw | 717 w | α(CCC) | |||||||||||
| 690 m | 690 m | 688 | 34.98 | 667 w | 667 w | 661 w | 685 s | 685 m | 698 w | 711 | 1.37 | 4 | γ(CH) | |||
| 643 | 26.91 | γCH2, βOCO | ||||||||||||||
| 697 | 31.63 | 678 | 67.30 | 6a | α(CCC) | |||||||||||
| 633 | 75.53 | 649 w | 654 w | 635 w | 634 | 84.84 | γOH | |||||||||
| 613 w | 615 vw | 614 w | 616 | 2.22 | 632 | 23.06 | 633 | 0.27 | 6b | α(CCC) | ||||||
| 578 w | 571 vw | 551 | 18.99 | 586 w | 584 vw | 578 w | 599 | 13.75 | α(CCC) + βOCO | |||||||
| 530 w | 520 vw | 519 | 50.95 | 632 | 75.83 | 510 | 56.63 | γOH, τCH2 | ||||||||
| 510 w | 502 vw | 502 | 3.98 | 557 | 2.23 | 506 vw | 505 | 1.28 | 16b | γ(CH)+γOH | ||||||
| 4-Chloro-2-Methylphenoxyacetic acid | 2,3-Dichlorophenoxyacetic acid | 2,4-Dichlorophenoxyacetic acid | Assignments | |||||||||||||
|---|---|---|---|---|---|---|---|---|---|---|---|---|---|---|---|---|
| Experimental | Calculated | Experimental | Calculated | Experimental | Calculated | |||||||||||
| FTIRKBR | FTIRATR | Raman | IR | Inten. | FTIRKBR | FTIRATR | Raman | IR | Inten. | FTIRKBR | FTIRATR | Raman | IR | Inten. | ||
| 3440 m | 3647 | 9658 | 3445 vs | 3689 | 99.09 | 3430 m | 3689 | 100.24 | ν(OH) | |||||||
| 3425 m | 3424 vs | 1 | ν(CH) | |||||||||||||
| 3054 m | 3053 w | 3058 m | 3146 | 4.02 | 3097 w | 3098 w | 3096 m | 3148 | 2.46 | 3152 | 1.41 | 2 | ν(CH) | |||
| 3078 s | 3144 | 3.60 | 3073 m | 3083 vs | 3149 | 1.85 | 20a | ν(CH) | ||||||||
| 3125 | 2.99 | 2987 w | 2981 w | 3119 | 5.30 | 2978 m | 2979 w | 2978 vs | 3136 | 3.79 | 20b | ν(CH) | ||||
| 3023 | 10.09 | βCH(CH3) | ||||||||||||||
| 2946 m | 2950 s | ν(CH) | ||||||||||||||
| 2925 m | 2929 w | 2930 vs | 2976 | 12.03 | 2920 w | 2918 w | 2920 m | 2985 | 10.14 | 2921 w | 2983 | 10.54 | νasCH2 | |||
| 2974 | 18.94 | νC-H(CH3) | ||||||||||||||
| 2942 | 36.01 | 2794 w | 2794 w | 2948 | 31.47 | 2755 w | 2758 w | 2946 | 32.51 | νsCH2 | ||||||
| 1743 s | 1743 s | 1739 w | 1813 | 300.52 | 1743 s | 1743 m | - | 1819 | 287.72 | 1735 s | 1729 s | 1856 | 295.96 | νC=O | ||
| 1708 m | 1706 m | 1704 w | 1708 s | 1706 m | - | 1709 m | νC=O | |||||||||
| 1637 w | 1636 w | 1640 w | 1600 | 9.25 | 1634 m | 1635 w | 1628 m | 1635 w | 1591 | 13.81 | 9a | β(CH), ν(CC) | ||||
| 1599 w | 1597 w | 1599 vs | 1587 | 1.86 | 1582 m | 1575 w | 1575 s | 1582 | 111.50 | 1585 w | 1585 w | 1593 s | 1604 | 8.27 | 9b | β(CH), ν(CC), |
| 1494 s | 1494 w | 1497 w | 1490 | 173.35 | 1482 | 212.96 | 18a | β(CH), ν(CC) | ||||||||
| 1450 w | 1449 w | 1449 w | 1452 | 72.69 | 1445 | 194.73 | 1449 m | 1449 m | 1445 s | 1451 | 116.57 | βCH2 | ||||
| 1448 | 8.42 | τCH3 | ||||||||||||||
| 1397 | 17.91 | 1460 s | 1460 m | 1458 m | 1478 s | 1477 s | 1481 w | 18b | β(CH), ν(CC)+ β CH2 | |||||||
| 1427 s | 1427 m | 1433 m | 1398 | 13.15 | 1430 m | 1429 s | 1428 m | 1398 | 7.81 | 1429 m | 1429 m | 1424 w | 1398 | 11.89 | γCH2 | |
| 1400 m | 1400 w | 1403 w | 1393 | 1.80 | βCH3 | |||||||||||
| 1383 m | 1379 w | 1378 m | 1383 m | 1392 w | 1385 m | 1391 w | 1393 w | 1385 | 14.58 | 15 | γCH2, νCCal, | |||||
| 1365 w | 1364 w | 1364 w | 1297 | 72.41 | 1362 vw | 1361 w | 1371 w | 1295 | 111.17 | 3 | β(CH), ν(CC) | |||||
| 1305 | 56.28 | α(CCC) | ||||||||||||||
| 1307 w | 1307 m | 1311 w | 1310 m | 1310 m | 1310 m | 1263 | 164.23 | 8b | β(CH), ν(CC) | |||||||
| 1286 | 1.00 | β(OH), γCH2 | ||||||||||||||
| 1297 m | 1297 m | 1297 m | 1284 | 2.52 | 1287 m | 1283 m | 1282 m | 1236 | 2.27 | β(CH), RC-O, γCH2 | ||||||
| 1271 | 10.10 | 1251 | 44.22 | β(CH) | ||||||||||||
| 1257 m | 1232 | 2.20 | 1270 m | 1272 s | 1260 m | 1260 m | 1258 s | 1236 | 2.31 | τCH2 | ||||||
| 1246 vs | 1246 vs | 1248 m | 1248 vs | 1253 m | α(CCC), νC-O | |||||||||||
| 1240 vs | 1238 vs | 1247 | 226.42 | 1232 vs | 1231 vs | 1234 m | α(CCC), νC-O | |||||||||
| 1194 vs | 1194 s | 1195 m | 1187 | 60.33 | 1195 w | 1195 w | 1195 m | 1194 | 3.53 | 1152 | 1.01 | 8a | β(CH) | |||
| 1137 s | 1137 s | 1130 w | 1143 | 0.24 | 1168 w | 1171 w | 1173 m | 1160 | 4.79 | 14 | β(CH) | |||||
| 1108 | 94.82 | 1158 w | 1160 w | 1160 s | 1123 | 202.77 | νC-OH, βCH2, βOH, | |||||||||
| 1115 m | 1114 | 407.98 | 1113 m | 1112 m | 1109 m | 1105 m | 1105 m | 1105 m | β(CH), βOH, | |||||||
| 1099 m | 1100 w | 1103 m | 1072 | 159.43 | 1088 s | 1085 s | 1093 s | 1092 s | 1082 | 343.92 | β(CH), νO-CH2 | |||||
| 1078 m | 1079 m | 1082 m | 1051 m | 1049 w | 1049 vs | 1048 w | 1048 w | β(CH) | ||||||||
| 1018 w | 1018 w | 1023 w | 1095 | 10.76 | 1027 w | 1027 w | 1026 w | 1096 | 65.39 | 19a | β(CH), ν(CC) | |||||
| 1042 | 1.65 | τCH3 | ||||||||||||||
| 997 | 11.27 | γCH3 | ||||||||||||||
| 995 w | 995 w | 1000 w | 1003 vw | 1043 | 42.00 | 1046 | 7.92 | 12 | α(CCC) | |||||||
| 1012 | 0.29 | 1013 | 0.35 | βCH2 | ||||||||||||
| 956 w | 950 w | 960 w | 947 | 0.26 | 5 | γ(CH) | ||||||||||
| 927 w | 928 s | 908 | 0.80 | 916 | 0.04 | 10b | γ(CH) | |||||||||
| 918 w | 913 m | 884 | 7.21 | 918 w | 915 m | 915 m | 889 | 9.56 | 915 w | 915 m | 885 | 5.15 | βO-CH2 | |||
| 888 w | 889 w | 899 w | 895 m | 895 s | 895 w | 895 m | 893 s | 17b | γ(CH) | |||||||
| 878 w | 878 m | 888 w | 873 | 19.37 | 861 vw | 861 w | 872 w | 871 m | 7 a | α(CCC) | ||||||
| 870 | 14.18 | 874 | 40.69 | 873 | 17.36 | 17a | γ(CH) | |||||||||
| 837 w | 837 w | 840 vs | 843 | 8.06 | 6 a | α(CCC) | ||||||||||
| 801 s | 803 vs | 799 m | 792 | 39.72 | 794 m | 794 s | 805 w | 795 | 39.38 | 10a | γ(CH) | |||||
| 755 vw | 755 w | 767 m | 766 s | 762 | 48.54 | 759 vw | 758 w | 11 | γ(CH) | |||||||
| 736 vw | 736 w | 731 | 7.93 | 721 m | 721 m | 718 s | 743 | 94.39 | α(CCC) | |||||||
| 685 m | 685 m | 680 m | 711 | 0.01 | 709 w | 711 m | 697 w | 697 m | 698 w | 730 | 0.53 | 4 | γ(CH) | |||
| 649 w | 654 w | 654 w | 635 | 84.75 | 646 w | 646 m | 647 s | γOH | ||||||||
| 616 vw | 613 w | 666 | 41.62 | 613 w | 613 w | 611 s | 668 | 31.46 | 596 w | 594 m | 656 | 19.65 | 6b | α(CCC) | ||
| 578 vw | 576 m | 609 | 18.02 | 568 w | 632 | 77.45 | 555 w | 560 m | 608 | 21.38 | α(CCC) + βOCO | |||||
| 554 w | 565 | 5.77 | 16b | γ(CH) | ||||||||||||
| 506 w | 508 w | 509 | 40.03 | 647 | 83.80 | γOH, τCH2 | ||||||||||
| 568 | 0.01 | 563 | 6.69 | 16a | γ(CH) | |||||||||||
| 474 vw | 441 | 3.22 | 474 w | 502 | 11.63 | 469 w | γ(CH)+γOH | |||||||||
| Water Solution C = 5 × 10−5 mol/dm3 | Methanol Solution C = 5 × 10−5 mol/dm3 | Assignments | ||||||||
|---|---|---|---|---|---|---|---|---|---|---|
| Experimental λmax [nm] | Theoretical λmax [nm] | Oscillator Strength (f) | Band Gap [eV] | Experimental λmax [nm] | Theoretical λmax [nm] | Oscillator Strength (f) | Band Gap [eV] | |||
| PA | 192 | 205 | 0.1330 | 6.1638 | 197 | 205 | 0.1323 | 6.1612 | H−1→LUMO H−1→L+1 H−1→L+2 HOMO→L+1 | π→π* |
| 216 | 216 | 0.0904 | 5.7355 | 217 | 216 | 0.0898 | 5.7351 | HOMO→L+2 H−1→ L+1 H−1→LUMO | π→π* | |
| 2CPA | 196 | 205.5 | 0.2421 | 6.0616 | 198 | 205.5 | 0.2421 | 6.0616 | H−1→LUMO H−1→L+1 H−1→L+2 HOMO→L+1 HOMO→L+2 | π→π* |
| 219 | 219.5 | 0.0585 | 5.6395 | 222 | 219.5 | 0.0512 | 5.6395 | HOMO→L+3 HOMO→L+2 HOMO→LUMO H−1→LUMO | π→π* | |
| 4CPA | 194 | 196 | 0.3547 | 6.3378 | 197 | 196 | 0.3511 | 6.6339 | H−1→LUMO H−1→L+1 H−1→L+2 HOMO→L+1 | π→π* |
| 226 | 224 | 0.2174 | 5.5260 | 225 | 224 | 0.2157 | 5.5263 | H−1→LUMO HOMO→L+1 HOMO→L+2 | π→π* | |
| 2,3D | 200 | 203.5 | 0.5249 | 6.1223 | 201 | 203.5 | 0.5267 | 6.1205 | H−1→LUMO H−1→L+1 HOMO→LUMO HOMO→L+3 | π→π* |
| 220 | 222 | 0.024 | 5.5861 | 221 | 222 | 0.028 | 5.5856 | HOMO→L+1 HOMO→L+2 H−1→LUMO H−1→L+2 | π→π* | |
| 2,4D | 200 | 204.5 | 0.6435 | 6.0795 | 198 | 204.5 | 0.6420 | 6.0772 | H−1→LUMO H−1→L+2 HOMO→L+1 | π→π* |
| 229 | 224 | 0.0812 | 5.5007 | 227 | 224 | 0.0796 | 5.5000 | H−1→L+1 HOMO→L+2 HOMO→L+3 | π→π* | |
| MCPA | 198 | 204.5 | 0.2453 | 6.1104 | 198 | 205 | 0.2441 | 6.1086 | H−1→LUMO H−1→L+1 H−1→L+2 HOMO→L+1 HOMO→L+2 | π→π* |
| 228 | 226 | 0.1658 | 5.4883 | 227 | 226 | 0.1651 | 5.4878 | H−1→LUMO HOMO→L+1 HOMO→L+2 | π→π* | |
| Atom | PA | 2CPA | 4CPA | 2,3D | 2,4D | MCPA | ||||||
|---|---|---|---|---|---|---|---|---|---|---|---|---|
| Exp | Calc | Exp | Calc | Exp | Calc | Exp | Calc | Exp | Calc | Exp | Calc | |
| C1 | 157.81 | 164.20 | 153.36 | 158.98 | 156.73 | 162.80 | 154.85 | 160.86 | 152.48 | 158.56 | 154.94 | 160.92 |
| C2 | 114.47 | 121.53 | 128.23 | 133.83 | 116.34 | 123.31 | 128.31 | 132.70 | 127.96 | 135.99 | 128.61 | 136.41 |
| C3 | 129.54 | 134.44 | 130.24 | 135.43 | 124.87 | 134.33 | 132.56 | 146.95 | 125.05 | 135.02 | 130.16 | 134.69 |
| C4 | 121.06 | 125.35 | 121.48 | 125.73 | 129.30 | 138.58 | 122.46 | 127.50 | 129.49 | 138.11 | 126.39 | 137.86 |
| C5 | 129.54 | 134.69 | 122.02 | 133.23 | 124.87 | 134.58 | 120.19 | 132.92 | 122.48 | 133.22 | 124.48 | 131.10 |
| C6 | 114.47 | 113.72 | 113.71 | 116.12 | 116.34 | 114.68 | 112.16 | 113.65 | 114.96 | 116.06 | 112.76 | 113.59 |
| C7 | 64.45 | 64.65 | 65.13 | 65.36 | 64.80 | 64.97 | 65.44 | 65.84 | 65.37 | 65.63 | 65.08 | 65.14 |
| C8 | 170.33 | 175.44 | 169.95 | 174.74 | 170.11 | 175.04 | 169.60 | 174.27 | 169.65 | 174.43 | 170.23 | 175.40 |
| H1 | 13.01 | 6.30 | 13.15 | 6.33 | 13.07 | 6.30 | 13.20 | 6.32 | 13.16 | 6.34 | 13.02 | 6.31 |
| H2 | 6.92 | 7.23 | - | - | 6.94 | 7.15 | - | - | - | - | - | - |
| H3 | 7.29 | 7.48 | 7.42 | 7.53 | 7.31 | 7.33 | - | - | 7.50 | 7.41 | 7.18 | 7.27 |
| H4 | 6.96 | 7.17 | 6.95 | 7.10 | - | - | 7.19 | 7.14 | - | - | - | - |
| H5 | 7.29 | 7.53 | 7.25 | 7.42 | 7.31 | 7.37 | 7.26 | 7.30 | 7.29 | 7.29 | 7.14 | 7.20 |
| H6 | 6.92 | 6.86 | 7.01 | 6.87 | 6.94 | 6.75 | 7.02 | 6.73 | 7.04 | 6.74 | 6.82 | 6.63 |
| H7 | 4.67 | 4.59 | 4.81 | 4.62 | 4.69 | 4.54 | 4.86 | 4.57 | 4.82 | 4.59 | 4.70 | 4.56 |
| H8 | 4.67 | 4.59 | 4.81 | 4.62 | 4.69 | 4.54 | 4.86 | 4.57 | 4.82 | 4.59 | 4.70 | 4.56 |
| Bacterial Strains | Bacillus megaterium ATCC 14581 | Pseudomonas aeruginosa ATCC 15442 | ||
|---|---|---|---|---|
| MIC | MBC | MIC | MBC | |
| Herbicides | mg/mL | |||
| PA | 1.56 | 1.56 | 3.13 | 3.13 |
| 2CPA | 1.56 | 1.56 | 3.13 | 3.13 |
| 4CPA | 0.78 | BS | 3.13 | 3.13 |
| 2,3D | 0.78 | 1.56 | 6.25 | 6.25 |
| 2,4D | 0.78 | 1.56 | 3.13 | 3.13 |
| MCPA | 0.39 | BS | 3.13 | 3.13 |
| Gentamycin | <1.91·10−6 | BS | 1.95·10−3 | NT |
| Rifampicin | <1.91·10−6 | BS | 1.60·10−2 | NT |
Disclaimer/Publisher’s Note: The statements, opinions and data contained in all publications are solely those of the individual author(s) and contributor(s) and not of MDPI and/or the editor(s). MDPI and/or the editor(s) disclaim responsibility for any injury to people or property resulting from any ideas, methods, instructions or products referred to in the content. |
© 2025 by the authors. Licensee MDPI, Basel, Switzerland. This article is an open access article distributed under the terms and conditions of the Creative Commons Attribution (CC BY) license (https://creativecommons.org/licenses/by/4.0/).
Share and Cite
Świderski, G.; Kowalczyk, N.; Tyniecka, G.; Kalinowska, M.; Łyszczek, R.; Bocian, A.; Ciszkowicz, E.; Siergiejczyk, L.; Pawłowska, M.; Czerwiński, J. Study of the Relationship Between the Structures and Biological Activity of Herbicides Derived from Phenoxyacetic Acid. Materials 2025, 18, 1680. https://doi.org/10.3390/ma18071680
Świderski G, Kowalczyk N, Tyniecka G, Kalinowska M, Łyszczek R, Bocian A, Ciszkowicz E, Siergiejczyk L, Pawłowska M, Czerwiński J. Study of the Relationship Between the Structures and Biological Activity of Herbicides Derived from Phenoxyacetic Acid. Materials. 2025; 18(7):1680. https://doi.org/10.3390/ma18071680
Chicago/Turabian StyleŚwiderski, Grzegorz, Natalia Kowalczyk, Gabriela Tyniecka, Monika Kalinowska, Renata Łyszczek, Aleksandra Bocian, Ewa Ciszkowicz, Leszek Siergiejczyk, Małgorzata Pawłowska, and Jacek Czerwiński. 2025. "Study of the Relationship Between the Structures and Biological Activity of Herbicides Derived from Phenoxyacetic Acid" Materials 18, no. 7: 1680. https://doi.org/10.3390/ma18071680
APA StyleŚwiderski, G., Kowalczyk, N., Tyniecka, G., Kalinowska, M., Łyszczek, R., Bocian, A., Ciszkowicz, E., Siergiejczyk, L., Pawłowska, M., & Czerwiński, J. (2025). Study of the Relationship Between the Structures and Biological Activity of Herbicides Derived from Phenoxyacetic Acid. Materials, 18(7), 1680. https://doi.org/10.3390/ma18071680










